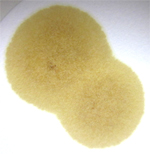

[세라토 1.5/1.6 2005] [5W30 SP] 세라토 블롯스팟테스트
 |
 심재은|냉동김치라면
심재은|냉동김치라면
2013-05-28 17:11 댓글:5 읽음:4779 49541포인트 112게시글 63댓글 추천한글 4 |

| 차종및년식 | 세라토 1.6 |
|---|---|
| 연료 | 가솔린 |
| 총주행거리 | 116,000 |
| 오일교환후주행거리 | 11,000 |
| 오일종류 | 5W30 SN |
| 주행여건 | 시내주행 90, 고속주행 10 |
| 시용후기 | 동생차 확인 해봤네요.. 오일떨어뜨려 놓고 3시간 반동안 모르고 신경 못 쓰고 있었네요.. 교체 할 시기가 됬을까요?? 상태로 봐서는 플러싱을 해줘야 할지 궁금 하네요.. 시내 주행만 하는데 5W20으로 할지 그냥 같은 점도로 갈지 고민입니다.. |

|
로얄퍼플|짱^0^
2013-05-28 18:28 1423921P |
오일이 잘못 떨어뜨려져있고 평평하지 않은곳에 두어서 식별이 조금 어렵긴 한데요
슬러지도 조금 보이구요... 점도도 다소 좋지 않아 보입니다.
교환후 주행거리에 비해 생각보다 상태가 않좋아 보입니다.
점도는 5W30이 제일 적합합니다 ^^
1안)
세라토를 오랫동안(3년이상) 더 타고 관리하실 생각이시면
플러싱 > EBI > HPS5W30 or 5W30SN적용
(지금 제가 적용하고 있구요 EBI적용중인데 훌륭한 결과를 보여주는 중입니다.차량은 뉴모닝이구요
EBI가 포인트구요 EBI에 인과아연의 함량이 높아 플러싱으로 표면처리를 해버리고 엔진의 실린더외 유막강화와 씰링작업을 통해 다시한번 엔진의성능을 회복시킨다는 목적입니다.)
2안)
경제적으로 무리를 하고싶진 않지만 그래도 관리를 염두해두신다면
플러싱 > HPS5W30 > HPS5W30 or 5W30SN
(HPS를 한번 적용하시는것이 포인트 입니다... 이후 5W30으로 가신다고 하더라도 오일내구성 및 차량성능이 많이 개선될것입니다)
3안)
그냥 합성유로 저렴하게 유지하고 싶어시다면
5W30SN
(1안과2안의 플러싱은 플러싱후 유막강화라는목적으로 플러싱을하는거구요 이 경우는 궂이 플러싱까지 하실 필요는 없으시구요(오히려 안좋을수 있습니다)
주의)플러싱은 약품플러싱을 하신다면 10분정도가 권장이라면 7~8분정도만 정확하게 돌리시면 됩니다.
시간은 직접 체크하셔야 합니다(샵 직원분들은 바쁘셔서 깜박하는경우가 있음)
분산성 : 3.5
부동액유입: 5
연료오염 : 5
슬러지 : 3.8




슬러지도 조금 보이구요... 점도도 다소 좋지 않아 보입니다.
교환후 주행거리에 비해 생각보다 상태가 않좋아 보입니다.
점도는 5W30이 제일 적합합니다 ^^
1안)
세라토를 오랫동안(3년이상) 더 타고 관리하실 생각이시면
플러싱 > EBI > HPS5W30 or 5W30SN적용
(지금 제가 적용하고 있구요 EBI적용중인데 훌륭한 결과를 보여주는 중입니다.차량은 뉴모닝이구요
EBI가 포인트구요 EBI에 인과아연의 함량이 높아 플러싱으로 표면처리를 해버리고 엔진의 실린더외 유막강화와 씰링작업을 통해 다시한번 엔진의성능을 회복시킨다는 목적입니다.)
2안)
경제적으로 무리를 하고싶진 않지만 그래도 관리를 염두해두신다면
플러싱 > HPS5W30 > HPS5W30 or 5W30SN
(HPS를 한번 적용하시는것이 포인트 입니다... 이후 5W30으로 가신다고 하더라도 오일내구성 및 차량성능이 많이 개선될것입니다)
3안)
그냥 합성유로 저렴하게 유지하고 싶어시다면
5W30SN
(1안과2안의 플러싱은 플러싱후 유막강화라는목적으로 플러싱을하는거구요 이 경우는 궂이 플러싱까지 하실 필요는 없으시구요(오히려 안좋을수 있습니다)
주의)플러싱은 약품플러싱을 하신다면 10분정도가 권장이라면 7~8분정도만 정확하게 돌리시면 됩니다.
시간은 직접 체크하셔야 합니다(샵 직원분들은 바쁘셔서 깜박하는경우가 있음)
분산성 : 3.5
부동액유입: 5
연료오염 : 5
슬러지 : 3.8

|
심재은|냉동김치라면
2013-05-28 19:39 49541P |
주행거리에 비해 상태가 안 좋은 이유가.. 교체 한지 1년 9개월 정도 지났습니다..
엔진오일 캡을 열어 보니 검은 슬러지 비슷한것도 눈에 보이더군요.. 이제 교체 할 시기는 됬다는 얘기죠..
무난하게 HPS 5W30을 생각 하고 있는데.. 플러싱 한번 하고 바로 HPS 5W30으로 가면 되겠네요..
차량 제원에 있는 오일양이 3.5 쿼터 정도 되는데.. 집에 보유 하고 있는 0.2쿼터와 3쿼터를 추가 구매 하면 될까요?
필터는 2808?? 로 하면 될거 같고.. 제 차가 아니다 보니 그렇게 비용을 들이는건 무리가 있습니다.
엔진오일 캡을 열어 보니 검은 슬러지 비슷한것도 눈에 보이더군요.. 이제 교체 할 시기는 됬다는 얘기죠..
무난하게 HPS 5W30을 생각 하고 있는데.. 플러싱 한번 하고 바로 HPS 5W30으로 가면 되겠네요..
차량 제원에 있는 오일양이 3.5 쿼터 정도 되는데.. 집에 보유 하고 있는 0.2쿼터와 3쿼터를 추가 구매 하면 될까요?
필터는 2808?? 로 하면 될거 같고.. 제 차가 아니다 보니 그렇게 비용을 들이는건 무리가 있습니다.
